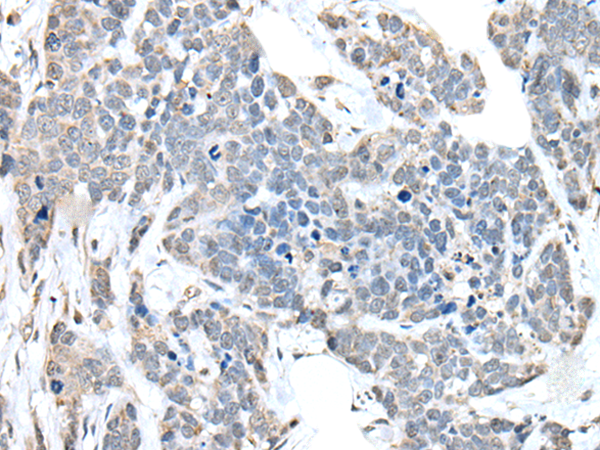
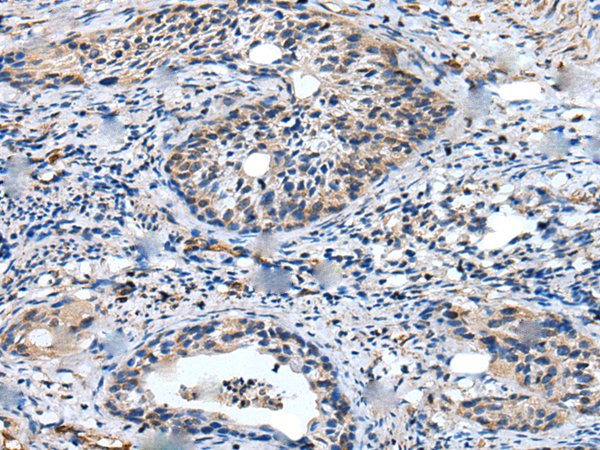

-
分类: 科研抗体货号: P09279别名: Mum2应用: IHC反应种属: Human, Mouse
-
分类: 科研抗体货号: P09280别名: VARP; PP12899应用: IHC反应种属: Human
-
分类: 科研抗体货号: P09278别名: WHSC2; NELF-A; P/OKcl.15应用: WB,IHC反应种属: Human, Mouse
-
分类: 科研抗体货号: P09277别名: PROF; WDF2; ZFYVE22应用: WB,IHC反应种属: Human, Mouse
-
分类: 科研抗体货号: P09276别名: C10orf64应用: IHC反应种属: Human
-
分类: 科研抗体货号: P09300别名: UBC3B; CDC34B; E2-CDC34B应用: IHC反应种属: Human, Mouse
-
分类: 科研抗体货号: P09293别名: RN; FP793; U2AF35; U2AFBP; RNU2AF1应用: WB,IHC反应种属: Human, Mouse
-
分类: 科研抗体货号: P09299别名: TULA; CLIP4; STS-2; TULA-1应用: IHC反应种属: Human, Mouse
-
分类: 科研抗体货号: P09292别名: U1A; Mud1; U1-A应用: WB,IHC反应种属: Human, Mouse
-
分类: 科研抗体货号: P09297别名: E1-L2; MOP-4; UBE1L2应用: IHC反应种属: Human

鄂公网安备42018502007531号
鄂公网安备42018502007531号

